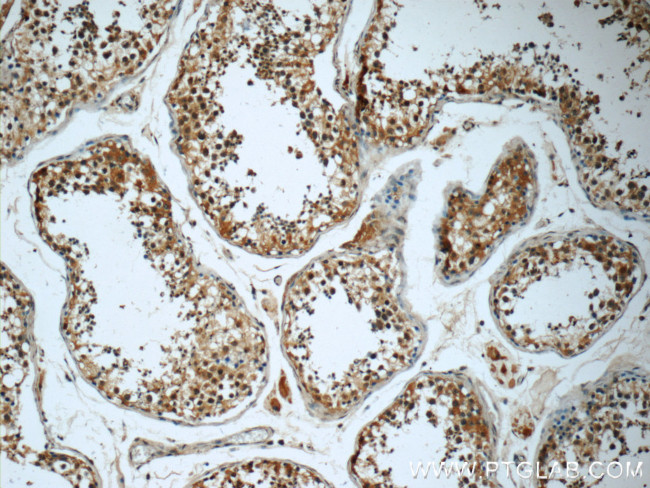
KIFAP3 Antibody in Immunohistochemistry (Paraffin) (IHC (P))

Search
Proteintech
KIFAP3 Monoclonal Antibody (7C9F2)
{{$productOrderCtrl.translations['antibody.pdp.commerceCard.promotion.promotions']}}
{{$productOrderCtrl.translations['antibody.pdp.commerceCard.promotion.viewpromo']}}
{{$productOrderCtrl.translations['antibody.pdp.commerceCard.promotion.promocode']}}: {{promo.promoCode}} {{promo.promoTitle}} {{promo.promoDescription}}. {{$productOrderCtrl.translations['antibody.pdp.commerceCard.promotion.learnmore']}}
产品信息
60266-1-IG
种属反应
宿主/亚型
分类
类型
克隆号
抗原
偶联物
形式
浓度
规格
纯化类型
保存液
内含物
保存条件
运输条件
产品详细信息
Immunogen sequence: SQHDGPTKN LFIDYVGDLA AQISNDEEEE FVIECLGTLA NLTIPDLDWE LVLKEYKLVP YLKDKLKPGA AEDDLVLEVV IMIGTVSMDD SCAALLAKSG IIPALIELLN AQQEDDEFVC QIIYVFYQMV FHQATRDVII KETQAPAYLI DLMHDKNNEI RKVCDNTLDI IAEYDEEWAK KIQSEKFRWH NSQWLEMVES RQMDESEQYL YGDDRIEPYI HEGDILERPD LFYNSDGLIA SEGAISPDFF NDYHLQNGDV VGQHSFPGSL GMDGFGQPVG ILGRPATAYG FRPDEPYYYG YGS (491-792 aa encoded by BC028679)
靶标信息
The small G protein GDP dissociation stimulator (smg GDS) is a regulator protein having two activities on a group of small G proteins including the Rho and Rap1 family members and Ki-Ras; one is to stimulate their GDP/GTP exchange reactions, and the other is to inhibit their interactions with membranes. The protein encoded by this gene contains 9 'Armadillo' repeats and interacts with the smg GDS protein through these repeats. This protein, which is highly concentrated around the endoplasmic reticulum, is phosphorylated by v-src, and this phosphorylation reduces the affinity of the protein for smg GDS. It is thought that this protein serves as a linker between human chromosome-associated polypeptide (HCAP) and KIF3A/B, a kinesin superfamily protein in the nucleus, and that it plays a role in the interaction of chromosomes with an ATPase motor protein. Several transcript variants encoding different isoforms have been found for this gene.
仅用于科研。不用于诊断过程。未经明确授权不得转售。
篇参考文献 (0)
生物信息学
蛋白别名: KAP-3; Kinesin-associated protein 3; small G protein GDP dissociation stimulator; Smg GDS-associated protein; unnamed protein product
基因别名: dJ190I16.1; FLA3; KAP-1; KAP-3; KAP3; KIF3AP; KIFAP3; SMAP; Smg-GDS
UniProt ID: (Human) Q92845, (Mouse) P70188
Entrez Gene ID: (Human) 22920, (Rat) 289168, (Mouse) 16579